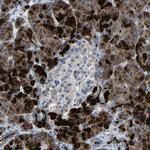
DCP1A Antibody in Immunohistochemistry (Paraffin) (IHC (P))
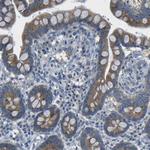
DCP1A Antibody in Immunohistochemistry (Paraffin) (IHC (P))

Search
Invitrogen
DCP1A Polyclonal Antibody
{{$productOrderCtrl.translations['antibody.pdp.commerceCard.promotion.promotions']}}
{{$productOrderCtrl.translations['antibody.pdp.commerceCard.promotion.viewpromo']}}
{{$productOrderCtrl.translations['antibody.pdp.commerceCard.promotion.promocode']}}: {{promo.promoCode}} {{promo.promoTitle}} {{promo.promoDescription}}. {{$productOrderCtrl.translations['antibody.pdp.commerceCard.promotion.learnmore']}}
图: 1 / 10
DCP1A Antibody (PA5-82478) in ICC/IF

Please note: We are reviewing Western blot images included in the antibody testing data in our catalog, including those provided by third parties. Unless expressly labeled or annotated as “raw-unedited”, Western blot images included in the antibody testing data in our catalog may have been edited, optimized or otherwise adjusted for presentation.
产品信息
PA5-82478
种属反应
宿主/亚型
分类
类型
抗原
偶联物
形式
浓度
规格
纯化类型
保存液
内含物
保存条件
运输条件
RRID
产品详细信息
Immunogen sequence: RSPLLNQPVP ELSHASLIAN QSPFRAPLNV TNTAGTSLPS VDLLQKLRLT PQHDQIQTQP LGKGAMVASF SPAAGQLATP ESFIEPPSKT AAARVAASAS LSNMVLAPLQ SMQQNQDPEV FVQPKVLSSA SA
Highest antigen sequence indentity to the following orthologs: Mouse - 83%, Rat - 82%.
靶标信息
Signal transduction of TGF-beta superfamily members is regulated by Smad proteins. In particular, Smads influence specific gene transcription by relaying signals from the cell membrane to the nucleus. Smad4 plays an essential role in TGF-beta-induced transcriptional activation wherein phosphorylated receptor-associated Smads associate with Smad4. Furthermore, SMIF (Smad4-intereacting protein) and Smad4 complex with TGF-beta and BMP4. An increase in Smad4 concentration increases the translocation of this complex to the nucleus. SMIF and Smad4 interact directly through a EVH1/WH1 domain on SMIF and a proline-rich activation domain on Smad4. Smad4 is essential to nuclear translocation of SMIF as deletion of the Smad4-interacting domain (located in the N-terminal 100 amino acids) of SMIF eliminates TGF-beta-induced nuclear translocation of SMIF. The human SMIF gene is ubiquitously expressed and encodes a protein with a relative molecular mass of 70 kDa.
仅用于科研。不用于诊断过程。未经明确授权不得转售。
篇参考文献 (0)
生物信息学
蛋白别名: FLJ21691; mRNA-decapping enzyme 1A; Smad4-interacting transcriptional co-activator; Transcription factor SMIF
基因别名: DCP1A; SMIF
Entrez Gene ID: (Human) 55802




